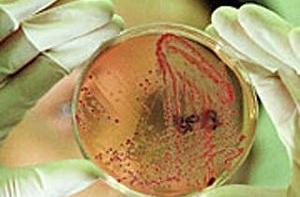
Российские ученые обнаружили новый тип бактерий

Читайте нас также
Арктический и Антарктический НИИ Росгидромета (ААНИИ) выпустил заявление, в котором говорится об обнаружении нового типа бактерий в подледниковом озере Восток в Антарктиде, которое в течение миллионов лет было изолировано от внешнего мира.
Ранее сотрудник лаборатории генетики эукариот Петербургского института ядерной физики (ПИЯФ) Сергей Булат сообщил РИА Новости, что исследование образцов воды, полученных в мае 2012 года из антарктического озера Восток, позволило выявить вид бактерий, которые не удалось идентифицировать.

«Находка осталась по настоящее время не идентифицированной и не классифицированной и может представлять один живой микроорганизм в водном (поверхностном) слое озера Восток», - говорится в сообщении ААНИИ.
В документе отмечается, что более чистые образцы воды озера Восток, замерзшей в скважине и разбуренной в нынешнем сезоне, будут доставлены в Петербург в мае 2013 года на борту судна «Академик Федоров».
«(Они) позволят подтвердить данную находку и, возможно, выявить другие неизвестные формы микроорганизмов, приспособленные к экстремальным условиям озера Восток, которое является единственным в своем роде земным аналогом подледных океанов на ледовых спутниках Юпитера (Европа, Ганимед, Калисто) или Сатурна (Энцелад)», - отмечается в заявлении.